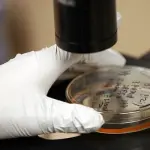
Prevotella, il batterio che cura la sclerosi multipla

Salute

Mangiare anguria previene il cancro
Redazione - 08 ago 2017

Le leccate del cane possono essere fatali
Redazione - 04 ago 2017

Mappato Dna spugne da cucina: peggio delle feci
Redazione - 01 ago 2017